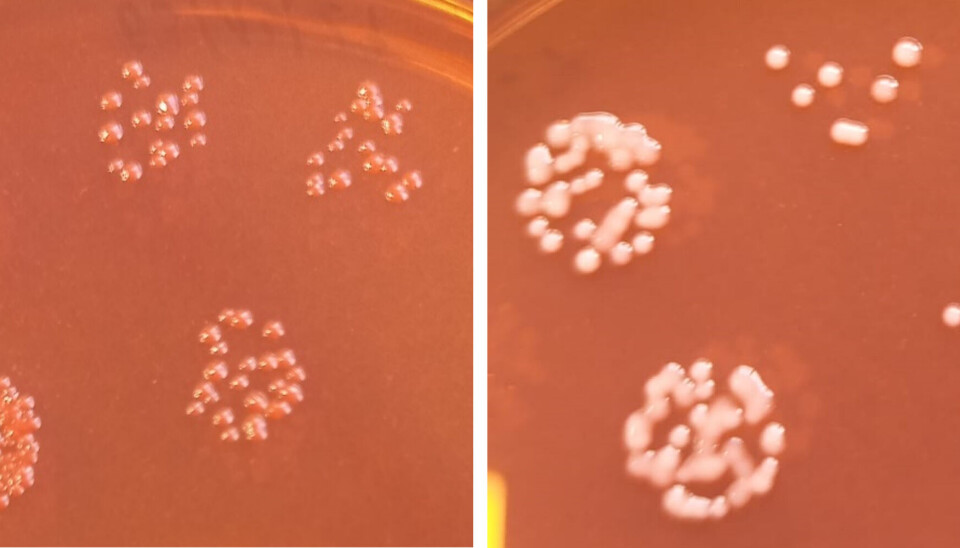

Hallazgo: Cepa emergente de Aeromonas salmonicida evade respuesta inmune en salmones
El surgimiento de esta nueva cepa de Aeromonas salmonicida, que al parecer evade la respuesta inmune, es responsable del aumento reciente de casos de furunculosis del salmón en Chile.
La incidencia de furunculosis atípica en Chile se ha incrementado en el último tiempo. Esta patología afecta, principalmente, a planteles de salmones en agua dulce, pero también a aquellos mantenidos en sistemas de recirculación (RAS).
Al hacer una actualización de un ensayo realizado por ADL Diagnostic en revista Salmonexpert, se detectó una nueva cepa en casos recientes de furunculosis. La cepa se caracterizó genética y fenotípicamente, así como también se determinó su virulencia.
También se demostró que la respuesta inmune inducida por las vacunas actuales no produce un nivel de anticuerpos importante contra el nuevo patógeno. Concluyen que el surgimiento de esta nueva cepa, que al parecer evade la respuesta inmune, es responsable del aumento reciente de casos de furunculosis en Chile.
Aeromonas salmonicida es una bacteria Gram negativa causante de furunculosis, una enfermedad septicémica que afecta principalmente a salmónidos a nivel mundial. El patógeno es un habitante de ambientes acuáticos que también puede afectar otros peces e incluso anfibios, casos que están ligados a cepas atípicas. Estas cepas conforman distintos taxones adicionales o subespecies, las cuales también se han aislado desde salmónidos.
Se reconocen hasta ahora 5 subespecies de A. salmonicida: A. salmonicida subp. salmonicida, A. salmonicida subp. achromogenes, A. salmonicida subp. masoucida, A. salmonicida subp. smithia y A. salmonicida subp. pectinolytica. Esta última, es la única subespecie que no proviene de casos clínicos, sino de muestras ambientales.
La furunculosis en el salmón se ha controlado mediante el uso de buenas prácticas de cultivo, tratamientos oportunos con antimicrobianos y vacunas, principalmente. El régimen habitual es vacunar planteles productivos con un producto multivalente que incluye A. salmonicida como antígeno. Sin embargo, a pesar de estas medidas, la incidencia de la enfermedad ha ido en aumento (Sernapesca 2023, 2024).
Durante 2022, algunos casos clínicos con signos patognomónicos de furunculosis resultaron negativos a nuestro ensayo de PCR, el cual se basa en la detección del gen vapA que codifica para la proteína estructural de la capa A. De dichos casos, se aislaron colonias que se guardaron para una caracterización subsecuente. Para determinar la causa de un posible fallo diagnóstico, se realizó una investigación abarcando diversos blancos de PCR descritos en literatura. Entre ellos, un método de PCR publicado por investigadores españoles se ha descrito como altamente específico para la identificación de A. salmonicida (Beaz-Hidalgo y col, 2008).
De acuerdo con lo anterior, en el presente trabajo se propone un esquema de detección por PCR para A. salmonicida que comprende 2 marcadores. Con este método, se logró caracterizar el cepario e identificar una nueva cepa, la cual carece del gen vapA.
Las consecuencias fenotípicas de dicho cambio se estudiaron más en profundidad, relacionándola a una composición particular de antígenos de membrana lo que conlleva a un título modesto en anticuerpos que confieren las vacunas actuales contra dicha cepa.
Para leer la información en detalla haga click aquí.